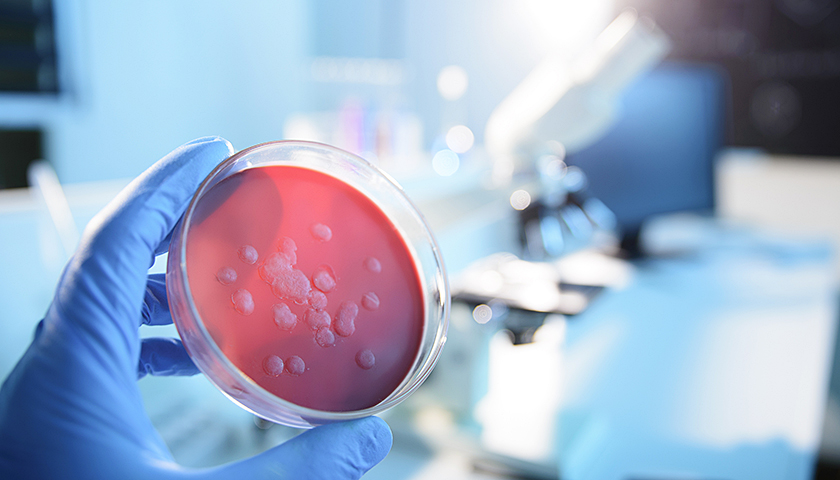
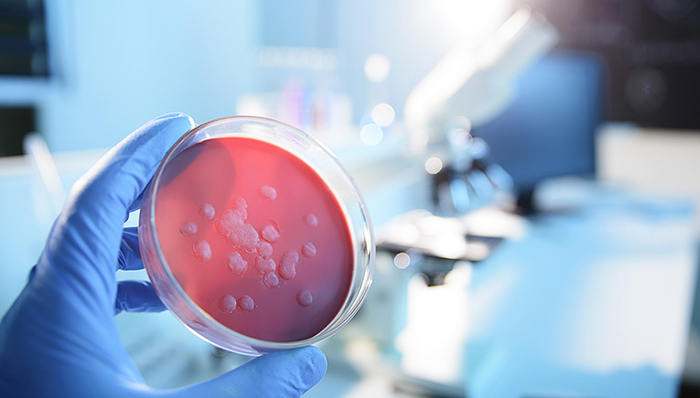
【界面晚报】中国疾控中心发文称鼠疫可控可治 银保监会针对中小银行挤兑风波再发声

中国疾控中心发文:鼠疫可控可治,北京市民不用过度担心
就公众关注的鼠疫问题,中国疾控中心2019年11月13日在官方微信发布《鼠疫可防可控》的文章,就什么是鼠疫、传播途径以及如何做好个人防护等做了详细介绍。详情点击>>
圆明园马首回归,由何鸿燊捐赠国家文物局
11月13日,文化和旅游部、国家文物局在中国国家博物馆举行圆明园马首铜像捐赠仪式。为更好践行流失文物回归原属地的文物保护国际共识,国家文物局经与何鸿燊先生协商一致,将马首划拨北京市圆明园管理处收藏,回归原属地。详情点击>>
刘鹤“定调”国企改革,专家称未来三年是政策落实关键期
据中国政府网消息,11月12日,国务院国有企业改革领导小组召开第三次会议,国务院副总理、国务院国有企业改革领导小组组长刘鹤出席会议并讲话。会议提出,未来三年是关键的历史阶段,要落实好国有企业改革顶层设计,抓紧研究制定国有企业改革三年行动方案,明确提出改革的目标、时间表、路线图。详情点击>>
银保监会针对中小银行挤兑风波再发声:祸起谣言,整体风险可控
11月12日,中国银保监会监管通气会上,城市银行部和农村银行部两位负责人就营口沿海银行和河南伊川农商行发生挤兑等风险事件表态。银保监会表示,当前银行保险业整体经营稳健,风险可控。有个别机构由于各种原因存在一些问题,这也与经济周期和自身经营治理存在缺陷有关系。详情点击>>
全球商业信心降至2009年金融危机以来最低
在贸易关系紧张、全球经济疲软的背景下,企业对商业前景的乐观度降至2009年金融危机以来最低。在新兴市场,经济预期下降主要出现在亚洲,在发达经济体,下降的趋势主要集中在美国。详情点击>>
200枚火箭弹来袭、450次空袭警报响起:以色列遭杰哈德报复还击
为报复以色列炸死巴勒斯坦伊斯兰圣战组织高级指挥官,加沙地带武装于11月12日向以色列发射了200多枚火箭弹,以色列全境拉响了450多次空袭警报。详情点击>>
美最高法院倾向支持废除DACA,特朗普:不少“梦想者”移民是罪犯
在一场最新举行的听证会上,美国最高法院的保守派法官倾向于支持特朗普废除对数十万在儿童时代非法进入美国的“梦想者”移民提供保护的计划。而只占据少数的自由派法官抱怨,此举是毁灭生命的选择。详情点击>>

评论